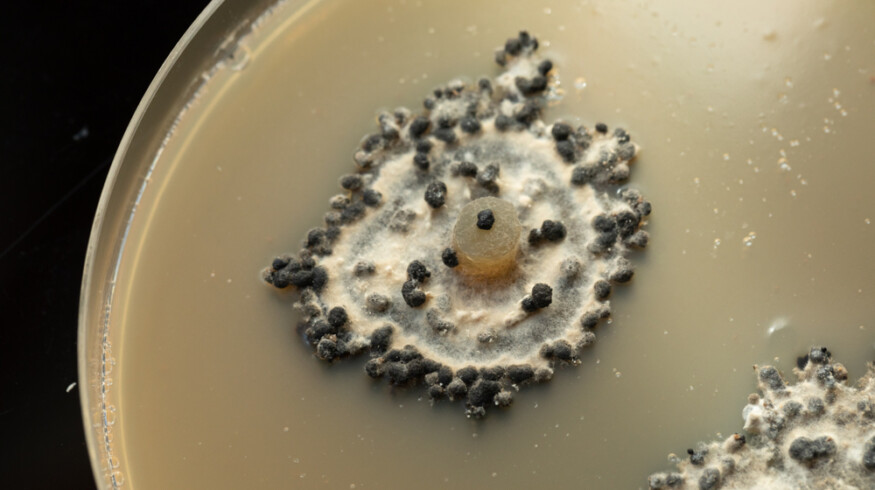
Soil fungus shows potential to replace chemical fungicides

Soil fungus shows potential to replace chemical fungicides
A common soil fungus may provide farmers with an alternative to synthetic fungicides, according to new research by Rothamsted scientists and their partners at the universities of Exeter and Warwick.
The study, published in Environmental Microbiology Reports, shows that Trichoderma hamatum GD12 — a fungus already used in crop protection — produces volatile organic compounds (VOCs) that can suppress devastating pathogens. When grown alongside Sclerotinia sclerotiorum, a mold that causes rot in lettuce, beans and oilseed rape, the fungus released a surge of airborne chemicals that stalled the pathogen’s growth.
Among the most potent was 1-octen-3-one, which not only halted S. sclerotiorum but also blocked other damaging fungi including Botrytis cinerea (grey mold), Pyrenopeziza brassicae (light leaf spot) and Gaeumannomyces tritici (wheat take-all). Laboratory tests showed VOC production peaked 17 days after the fungi were grown in co-culture.

The findings come as regulators in Europe and the UK tighten restrictions on synthetic fungicides, pushing the agriculture sector to seek greener solutions. “Further work is needed to understand how these fungal VOCs operate in real-world farming conditions, and whether they can be harnessed effectively at scale,” said Dr. József Vuts of Rothamsted, a co-author of the study. “But the discovery offers fresh hope for greener crop protection at a time when agriculture is under pressure to cut chemical inputs.”
Industry observers say such discoveries could feed into the development of commercial biocontrol products, an expanding market as agrochemical companies search for new tools to meet sustainability and regulatory demands.
Enjoyed this story?
Every Monday, our subscribers get their hands on a digest of the most trending agriculture news. You can join them too!









Discussion0 comments